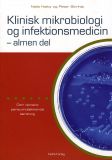
9788777495465

Søgeresultater for: 'undg vold p arbejdspladsen'
-

Hjem/By/Ting
Af: Mia Degner, Amalie Laulund Trudså, Bue P. Peitersen
Indbinding: Hæftet
Forlag: Forlaget Korridor
Første udgave:
2014
ISBN-13:
9788792655431
Oplagsdato:
2. jan. 2014
150,00 kr
-
-
-

Du er ikke alene
Af: Kenneth Bøgh Andersen, Kirsten Sonne Harild, Ida-Marie Rendtorf
Indbinding: Hardback
Forlag: Børn, Unge & Sorg
ISBN-13:
9788799381340
Oplagsdato:
12. nov. 2013
28,75 kr
-

Vi vil giftes katolsk
Af: Jacob Bang, Johanna Bos, p. Allen Courteau OMI, Kaare Nielsen, C
Indbinding: Paperback
Forlag: Ansgarstiftelsen
Første udgave:
2012
ISBN-13:
9788791338335
Oplagsdato:
27. aug. 2012
148,75 kr
 Hjem/By/TingIndbinding: HæftetForlag: Forlaget KorridorFørste udgave: 2014ISBN-13: 9788792655431Oplagsdato: 2. jan. 2014150,00 krUdsolgt
Hjem/By/TingIndbinding: HæftetForlag: Forlaget KorridorFørste udgave: 2014ISBN-13: 9788792655431Oplagsdato: 2. jan. 2014150,00 krUdsolgt Bogpakke: Som kunstnerne så Aarhus og Østbanegården i ÅrhusIndbinding: HardbackForlag: Århus Byhistoriske FondFørste udgave: 2014ISBN-13: 9788791324055Oplagsdato: 1. jan. 2014198,75 krUdsolgt
Bogpakke: Som kunstnerne så Aarhus og Østbanegården i ÅrhusIndbinding: HardbackForlag: Århus Byhistoriske FondFørste udgave: 2014ISBN-13: 9788791324055Oplagsdato: 1. jan. 2014198,75 krUdsolgt Klinisk mikrobiologi og infektionsmedicin - almen delIndbinding: PaperbackForlag: FADLISBN-13: 9788777495465Oplagsdato: 4. mar. 2009100,00 kr
Klinisk mikrobiologi og infektionsmedicin - almen delIndbinding: PaperbackForlag: FADLISBN-13: 9788777495465Oplagsdato: 4. mar. 2009100,00 kr Du er ikke aleneIndbinding: HardbackForlag: Børn, Unge & SorgISBN-13: 9788799381340Oplagsdato: 12. nov. 201328,75 krUdsolgt
Du er ikke aleneIndbinding: HardbackForlag: Børn, Unge & SorgISBN-13: 9788799381340Oplagsdato: 12. nov. 201328,75 krUdsolgt Vi vil giftes katolskIndbinding: PaperbackForlag: AnsgarstiftelsenFørste udgave: 2012ISBN-13: 9788791338335Oplagsdato: 27. aug. 2012148,75 krUdsolgt
Vi vil giftes katolskIndbinding: PaperbackForlag: AnsgarstiftelsenFørste udgave: 2012ISBN-13: 9788791338335Oplagsdato: 27. aug. 2012148,75 krUdsolgt